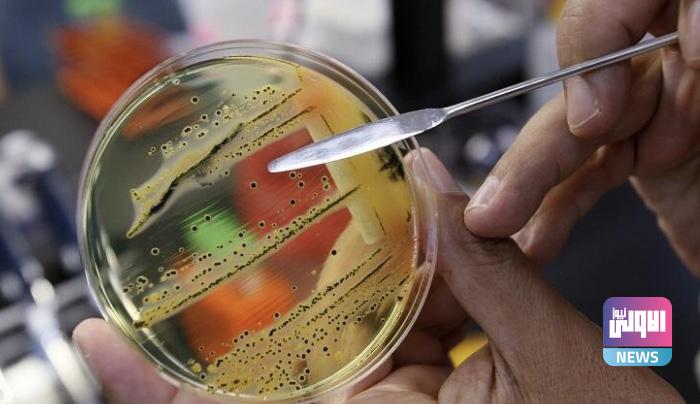

وباء اشد فتكا من كورونا ناتج عن خطا بشري.. تعرف عليه
لم يغفل الطبيب وعالم الأحياء البريطاني، ألكسندر فلمنغ، أثناء تسلمه جائزة نوبل عن اكتشافه أول مضاد حيوي عرفه العالم، التحذير من استشراء قدرة البكتيريا على تطوير نفسها لتصبح مقاومة للمضاد الحيوي في حال تم الإفراط في استخدام بعض من تلك المضادات.
وبعد مرور أكثر من 90 عاماً على الثورة التي أحدثها اكتشاف البنسلين في مجال الطب الحديث والرعاية الصحية، وصفت منظمة الصحة العالمية الميكروبات المقاومة للمضادات الحيوية بأنها “أكثر المخاطر الصحية إلحاحا في عصرنا الحديث”، إذ تهدد “بالارتداد نحو قرن إلى الوراء” عما بلغه العالم من تقدم طبي.
وتشير تقارير منظمة الصحة العالمية إلى أن استهلاك العالم من المضادات الحيوية شهد قفزة هائلة منذ بداية الألفية الثالثة؛ إذ رصدت المنظمة استخدام نحو 34.8 مليار جرعة من المضادات الحيوية كل عام، مع زيادة الاستهلاك العالمي بنسبة 65 في المائة بين عامي 2000 و2015.
وتعتبر المنظمة إساءة استعمال مضادات الميكروبات والإفراط في استعمالها المحركين الرئيسين لظهور الميكروبات المقاومة للأدوية، والتي وصفتها المنظمة العالمية بأنها “وباء غير مرئي” قد يكون “أشد فتكاً على المدى الطويل من فيروس كورونا”؛ إذ يُتوقع أن تتسبب في وفاة نحو 10 ملايين شخص سنويا.
وتتمثل خطورة الإفراط في استخدام تلك العقاقير ومن ضمن الأخطاء البشرية الشائعة في أنها تسمح للبكتيريا والميكروبات بتطوير نفسها لتصبح مقاومة للمضادات الحيوية؛ إذ يموت نحو 700 ألف شخص في العالم، بينهم 300 ألف طفل حديث الولادة، كل عام، بسبب عدم فاعلية العقاقير المقاومة للالتهابات، وتشير التوقعات إلى أن الأرقام آخذة في الارتفاع.
وإذا كانت التقارير العالمية تشير إلى أن واحدا من كل خمسة مضادات حيوية تُوصف، في بريطانيا، وواحدا من بين كل ثلاثة مضادات تُوصف في الولايات المتحدة، دون داعٍ طبي؛ فإن الواقع في الدول العربية أكثر قتامة؛ إذ لا يتطلب الحصول على تلك العقاقير، في أغلب تلك البلدان، وصفة طبية.
وتشير نتائج استطلاع الرأي الذي أجريناه في العاصمة الأردنية إلى أن غالبية المواطنين يلجؤون لشراء المضادات الحيوية من الصيدليات، لدى شعورهم بأعراض نزلات البرد، ودون حتى اللجوء للطبيب للحصول على تشخيص؛ إذ يكاد ينعدم الوعي بالنتائج الكارثية لإساءة استخدام تلك العقاقير لدى المواطن العربي.




